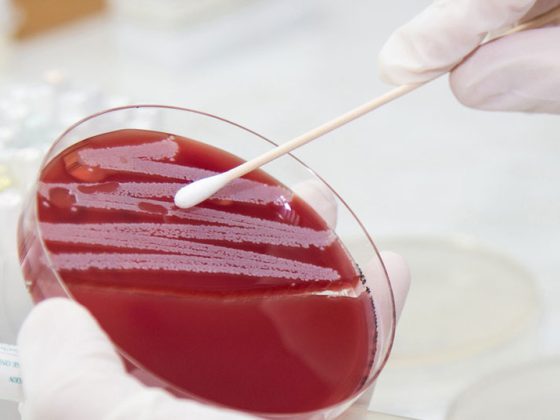

La plèvre est une couche séreuse qui recouvre les organes thoraciques et la face interne du squelette vers la cavité thoracique. La petite quantité normale de liquide pleural, responsable d’un glissement pleural sans irritation, est principalement produite dans la plèvre pariétale et résorbée par les voies lymphatiques.
La plèvre est une couche séreuse qui recouvre les organes thoraciques et la face interne du squelette vers la cavité thoracique. La pression négative physiologique dans l’espace pleural pour maintenir une pression transpulmonaire positive est de -3-5 cm H2O. La petite quantité normale de liquide pleural, responsable d’un glissement pleural sans irritation, est à la fois produite et résorbée par les voies lymphatiques, principalement dans la plèvre pariétale. Cette capacité peut être multipliée par 20 en fonction des besoins. Un épanchement pleural significatif n’apparaît donc qu’en cas d’augmentation significative de la quantité de liquide produite ou de réduction de la capacité de résorption. Le diaphragme joue à cet effet le rôle d’une pompe, qui contribue également à l’homéostasie pleurale.
L’échographie du thorax et de la plèvre doit idéalement être réalisée en position assise. L’échographie permet alors de voir environ 70% de la plèvre, les parties de la plèvre cachées par les côtes pouvant souvent être vues en inclinant le transducteur. Pour obtenir une vue d’ensemble, l’examen doit commencer par un transducteur convexe (3-5 MHz). Pour une évaluation plus détaillée des structures proches du transducteur sur la paroi thoracique, l’utilisation supplémentaire d’un transducteur linéaire à plus haute fréquence peut alors être utile. Les ondes sonores sont réfléchies par des interfaces présentant une différence d’impédance élevée, de sorte que la surface des côtes ainsi que la plèvre viscérale constituent une barrière naturelle de l’imagerie par ultrasons.
Pleurasono, la méthode de détection la plus sensible
La détection de liquide dans la cavité pleurale a été l’une des premières questions de l’échographie clinique et reste aujourd’hui encore l’une des plus importantes. Même les plus petites quantités de liquide sont détectables par échographie, bien plus tôt que sur un scanner ou même une radiographie. Il existe plusieurs formules simples pour quantifier la quantité d’épanchement, ce qui peut être particulièrement important pour les contrôles de l’évolution. Pour cela, il est important de pouvoir reproduire la position de l’examen et du transducteur. Dans la pratique clinique quotidienne, par exemple, une mesure simple de la hauteur de l’épanchement sous-pulmonaire, c’est-à-dire la distance entre le bord inférieur du poumon et le diaphragme, est tout à fait praticable : cela permet de faire la distinction entre un épanchement faible (<2 cm), modéré (2-5 cm) et important (>5 cm). Avec l’expérience croissante de l’examen, il s’agit d’une procédure suffisante pour la routine clinique, car la quantité absolue d’épanchement ne joue généralement aucun rôle. Toutes les formules d’estimation du volume ne peuvent être appliquées qu’aux épanchements pleuraux à écoulement libre et non aux épanchements pleuraux encapsulés ou cloisonnés.
Les épanchements pleuraux peuvent avoir de nombreuses causes. L’échographie de l’épanchement ne fournit souvent pas à elle seule des informations suffisantes pour déterminer la cause de l’épanchement. Toutefois, l’échographie présente des avantages considérables, notamment par rapport à la tomodensitométrie :
- Absence de rayonnement,
- une bien meilleure représentation des structures solides délicates dans l’épanchement,
- en tant que méthode en temps réel, une évaluation dynamique supplémentaire du glissement pulmonaire ainsi que de la ventilation et de la circulation sanguine.
La cause de l’atélectasie peut souvent être différenciée par l’échographie
Des épanchements plus importants entraînent un déplacement caudal du diaphragme et les poumons adjacents – initialement le lobe inférieur – sont comprimés. Cette atélectasie par compression homogène se déplace dans l’épanchement en synchronisation avec la respiration et le pouls (ce que l’on appelle le “doigt qui remue”) et peut souvent être partiellement réaérée en cas d’inspiration profonde (figure 1A). En cas de dyspnée, une thoracocentèse thérapeutique permet d’obtenir une expansion rapide et de soulager les symptômes. En revanche, en cas d’obstruction centrale des voies respiratoires (par exemple par une tumeur, des sécrétions ou un corps étranger), il existe une atélectasie obstructive qui apparaît moins comprimée et à peine mobile (figure 1B). Souvent, il est également possible de visualiser les bronches remplies de liquide suite à la rétention de sécrétions (bronchogramme fluide). L’épanchement pleural est généralement moins important en cas d’atélectasie obstructive, une ponction d’épanchement thérapeutique pour soulager la dyspnée n’est pas efficace tant que la cause bronchique n’est pas également corrigée.
Des indications échographiques supplémentaires sur la genèse de l’épanchement peuvent être obtenues par des résultats concomitants dans des structures voisines (tableau 1).

Ponction pleurale sous contrôle échographique
Tout épanchement pleural doit faire l’objet d’une ponction diagnostique unique. En cas d’épanchement bilatéral, il convient de procéder à une séparation latérale et, le cas échéant, à un double examen, car les causes peuvent être différentes. Les ponctions d’épanchement et les installations de drainage sont effectuées au niveau du bord supérieur des côtes. Les éventuels trajets vasculaires aberrants doivent être exclus par l’échographie avant la ponction. Cela permet généralement d’éviter de manière fiable une lésion des vaisseaux intercostaux et des troncs nerveux.
La surveillance de la ponction peut se faire – comme pour la ponction vasculaire – par la visualisation continue de l’instrument de ponction introduit, en veillant à une stérilité absolue en cas de contact éventuel de l’instrument de ponction avec le transducteur. En revanche, pour de grandes quantités de liquide, un marquage échographique du site de ponction est également suffisant.
Pour évaluer l’épanchement, on distingue un transsudat et un exsudat sur la base du profil paraclinique de l’épanchement, en se basant sur les critères de Light. Les paramètres essentiels à cet égard sont les rapports sérum/épanchement de protéines, de glucose et de LDH. Un épanchement pleural inexpliqué doit également faire l’objet d’un examen microbiologique, mais celui-ci ne permet souvent pas de déterminer avec certitude l’agent pathogène. Une amélioration de la sensibilité est souvent obtenue par une biopsie supplémentaire de la plèvre pariétale pour l’observation microbiologique du matériel.
Afin d’éviter un œdème de réexpansion cliniquement significatif, il est courant de limiter le volume de ponction possible en une seule séance à 1-1,5 litre, bien que les données ne fournissent pas de preuves irréfutables à cet égard. Pour les épanchements plus importants, il est donc préférable de procéder à un drainage fractionné à l’aide d’un cathéter à lumière fine, ce qui permet d’éviter un nouveau traumatisme de la ponction. Celui-ci peut par exemple être placé selon la technique de Seldinger.
Après la ponction, un contrôle par imagerie est toujours nécessaire pour exclure un pneumothorax. Pour cela aussi, il convient d’apprendre à utiliser l’échographie et de renoncer à l’imagerie radiographique. En particulier, avec un peu de pratique, l’échographie permet d’exclure un pneumothorax de manière plus fiable que la radiographie.
L’échographie détaillée est utile pour des questions spécifiques
Une échographie détaillée peut fournir des indications supplémentaires pour les questions suivantes :
Epanchement parapneumonique, empyème : environ la moitié des patients atteints de pneumonie développent des épanchements pleuraux parapneumoniques. Cliniquement, cela peut être suspecté dès qu’une douleur pleurétique initiale est suspendue lors d’une pneumonie. Il s’agit le plus souvent d’épanchements passagers, étroits et peu complexes. Cependant, dans 10% des cas, il s’ensuit un épanchement pleural plus important et plus compliqué ou un empyème pleural. C’est pourquoi les pleuropneumonies sévères en particulier devraient être contrôlées par imagerie au cours du traitement, l’idéal étant alors de pouvoir utiliser une échographie comme résultat initial à titre de comparaison.
L’échographie permet de bien distinguer les différents stades de l’épanchement parapneumonique et de l’empyème pleural, et même mieux que la tomodensitométrie (tableau 2).

Tumeurs pleurales : on distingue les tumeurs pleurales bénignes et les tumeurs pleurales malignes. Les modifications malignes, nettement plus fréquentes sur le plan clinique, sont divisées en modifications primaires et secondaires.
L’échographie révèle un élargissement de la plèvre pariétale, qui peut atteindre nettement >1 cm en cas de malignité, présente une surface instable, provoque parfois des modifications nodulaires et peut s’incruster dans la paroi thoracique. L’échographie duplex ou l’utilisation d’un produit de contraste ultrasonique permet de détecter les néovascularisations pathologiques. L’examen doit être réalisé à l’aide d’un scanner linéaire et d’une fréquence sonore élevée, car cela permet d’obtenir une résolution optimale à courte distance.
Mésothéliome pleural : Dans le cas de la malignité pleurale primaire, le mésothéliome pleural est une maladie rare. Elle est parfois sporadique et beaucoup plus souvent associée à des antécédents d’exposition à l’amiante. La symptomatologie clinique évolue lentement et n’est pas caractéristique au départ. Les signes échographiques d’un mésothéliome sont une masse tumorale importante et une infiltration de la paroi thoracique (et les douleurs qui en découlent).
Les épanchements pleuraux malins surviennent chez jusqu’à 15% des patients atteints de tumeurs, sont associés à une morbidité et une mortalité accrues et marquent souvent le passage à un stade palliatif de la tumeur. Les causes extrathoraciques fréquentes sont le carcinome mammaire, le carcinome gastrique et les lymphomes. Il est vrai que la ponction ne permet souvent pas de mettre en évidence la malignité : La sensibilité et la spécificité de la cytologie de l’épanchement, toutes entités tumorales confondues, ne sont que de 58 et 97% respectivement. Un résultat échographique typique de la plèvre pariétale peut aider à remettre en question les résultats cytologiques faussement négatifs et à poser l’indication d’une thoracoscopie. La plèvre présente alors plus souvent des épaississements nodulaires et non homogènes, de préférence dorso-basale et également sur la partie diaphragmatique (Fig. 2). Un élargissement, en particulier de plus de 10 mm, est suspect de malignité jusqu’à preuve du contraire. En particulier, les épanchements unilatéraux et de grand volume inexpliqués doivent faire penser à une malignité.

La première étape doit donc consister en une ponction d’épanchement diagnostique. Cependant, en particulier en cas d’antécédents d’amiante, des méthodes alternatives de prélèvement de tissus histologiques doivent être envisagées rapidement ou dès le début, afin d’augmenter le rendement et la sécurité des épaississements pleuraux spécifiques de la malignité. En cas de doute, une thoracoscopie est toutefois indiquée, au cours de laquelle une pleurodèse peut être effectuée en plus de la confirmation du diagnostic. De même, avant une thoracoscopie, le positionnement des trocarts doit être vérifié par échographie juste avant leur mise en place.
Capacité d’expansion avant thoracocentèse
La dyspnée est fréquente en cas d’épanchement pleural volumineux et rapidement récidivant. Avant de procéder à une thoracocentèse thérapeutique, il faut d’abord déterminer si l’épanchement et les poumons sont encore suffisamment mobilisables, en particulier en cas d’épanchement malin. Dans le cas contraire, les poumons attachés risquent de former un séropneumothorax, qui se remplirait à nouveau de liquide. Cette constellation est appelée “trapped lung ” – poumon enchaîné. L’absence d’inflation inspiratoire ou la réduction de la motilité synchrone du pouls, qui peut être documentée par l’utilisation du mode M, peuvent être des indices préalables. Une autre possibilité, bien que nettement plus complexe, consiste à mesurer la pression intrapleurale. Si la ponction n’est pas critique, il se formera sinon un pneumothorax ex vacuo qui se remplira à nouveau rapidement de liquide en raison du manque d’expansion. Dans ce cas, la pleurodèse chimique primaire n’a pas non plus de chances de succès, de sorte qu’il convient de mettre en place un cathéter pleural tunnelisé ou, en fonction de l’état général, de tenter une décortication chirurgicale thoracique des masses tumorales situées dans les viscères.
Pneumothorax : l’échographie thoracique est une méthode au moins équivalente à la radiographie du thorax, en particulier pour exclure un pneumothorax, et fait partie des lignes directrices allemandes sur le pneumothorax mises à jour en 2018. Les études sont claires et montrent une sensibilité plus élevée et une spécificité comparable. En particulier en position couchée sur le dos, par exemple chez les patients en soins intensifs ou après des interventions telles que le prélèvement de tissus par bronchoscopie ou la pose d’un cathéter veineux central (port, CVC), il faut prendre l’habitude d’utiliser l’échographie côté lit comme méthode de premier choix pour exclure un pneumothorax. Le choix du transducteur est généralement secondaire, car toutes les variantes de transducteurs permettent de reconnaître les caractéristiques énumérées ci-dessous. Les dispositifs de poche, qui peuvent être connectés à des tablettes ou à des téléphones portables, devraient à nouveau faciliter considérablement les choses.
Caractéristiques simples du pneumothorax
En utilisant une procédure d’enquête schématique, les critères suivants doivent être traités :
- Glissement pleural – Glissement des feuillets pleuraux en synchronisation avec la respiration, avec éventuellement mise en évidence de lignes B ou de structures résistantes à la pleurésie. Additif Utilisation possible du mode M avec détection du signe Seashore en cas de résultat normal ou du signe du code-barres en cas de pneumothorax (Fig. 3).
- Pouls pulmonaire – pulsation synchrone de la plèvre viscérale, détectable directement ou à l’aide d’un doppler couleur.
- Point pulmonaire – Point de transition entre le pneumothorax et la plèvre viscérale adjacente, déplacé en synchronisation avec la respiration, visible uniquement en cas de pneumothorax partiel.

La tête de l’échographe est placée au point le plus haut du thorax (en fonction de la position ! En position dorsale : ventrale en position de Monaldi). Si le glissement pleural et/ou un pouls pulmonaire peuvent être détectés ici via les espaces intercostaux adjacents, un pneumothorax est pratiquement exclu. L’absence de ces critères ne constitue toutefois pas une preuve certaine de pneumothorax. En particulier, le glissement pleural peut être fortement limité ou supprimé en cas d’hyperinflation pulmonaire, de grandes bulles, sous ventilation invasive (en particulier la ventilation par jet) et en cas d’adhérences pleurales (après empyème ou opération préalable). En l’absence de preuve de glissement pleural et de pouls pulmonaire, un point pulmonaire est alors recherché par déplacement latéral dans l’espace intercostal correspondant. Si celui-ci est détectable, cela prouve la présence d’un pneumothorax.
En raison des sources d’erreur décrites, il est judicieux de présenter le résultat initial avant l’intervention et de toujours comparer les côtés. Si les résultats ne sont pas clairs, une imagerie alternative doit être réalisée.
Il n’est toutefois pas possible d’estimer de manière fiable la taille d’un pneumothorax par échographie. La décision de traitement doit être prise dans le contexte de l’état clinique et de la genèse du pneumothorax. Par exemple, un pneumothorax post-interventionnel peut être traité de manière conservatrice si un point pulmonaire est détecté et que le patient est asymptomatique, si un contrôle clinique et échographique peut être rendu possible à court terme. Pour ce faire, l’emplacement du point pulmonaire est marqué sur la peau et contrôlé à court terme. Ainsi, la dynamique du pneumothorax est reconnaissable. Le succès du traitement par drainage ou aspiration unique peut également être suivi par échographie et ne nécessite pas nécessairement une radiographie.
Messages Take-Home
- L’échographie est la principale méthode d’imagerie utilisée pour détecter et quantifier les épanchements pleuraux.
- Les caractéristiques échographiques dans l’épanchement, sur la plèvre pariétale ou sur les poumons sont utiles pour la différenciation étiologique.
- La localisation du site de ponction de l’épanchement pleural est nécessaire à l’échographie afin d’éviter les lésions accidentelles des structures vasculaires et du tissu pulmonaire.
- Le pneumothorax post-interventionnel doit être exclu par échographie au niveau du lit. Il est donc souvent possible de se passer d’une radiographie.
- Une échographie unique doit être réalisée pour chaque pneumonie. Les épanchements parapneumoniques importants doivent être ponctionnés pour les soulager, les petits épanchements doivent être contrôlés par échographie.
- En l’absence de pneumothorax, les douleurs thoraciques après une ponction pleurale censée soulager le patient indiquent une absence de capacité d’expansion.
- Un pneumothorax peut être exclu avec certitude par l’échographie, mais parfois non prouvé. L’extension du pneumothorax ne peut pas être évaluée avec certitude par l’échographie.
Littérature :
- Beckh S, Blank W, Kubale R et al. Norme d’examen pour l’échographie transthoracique Ultrasons en médecine – European Journal of Ultrasound 2006 ; 27(03) : 287-288.
- Volpicelli G, Elbarbary M, Blaivas M et al. International evidence-based recommendations for point-of-care lung ultrasound. Soins intensifs Med 2012 ; 38 : 577-591.
- Société allemande de pneumologie et de médecine respiratoire (DGP), Société allemande d’infectiologie (DGI), (PEG) P-E-GfCeV. Ligne directrice S3 “Traitement des patients adultes atteints de pneumonie acquise en ambulatoire et prévention – Mise à jour 2016”. In : (AWMF) AdWMF ed. www.awmf.org/leitlinien/detail/ll/020-020.html ; 2016
- Schnell J, Beer M, Eggeling S, et al. : Prise en charge du pneumothorax spontané et du pneumothorax post-interventionnel : Guide S3 allemand. Zentralblatt fur Chirurgie 2018 ; 143 : S12-s43.
- Joyner Jr. CR, Herman JR, Reid JM : Ultrasound réfléchi dans la détection et la localisation de l’effusion pleurale. JAMA 1967 ; 200 : 399-402.
- Light RW, Macgregor MI, Luchsinger PC, et al : Effusions pleurales : la séparation diagnostique des transudats et des exudats. Annals of internal medicine 1972 ; 77 : 507-513.
- Tasci S, Ewig S, Lüderitz B : Diagnostic et traitement des épanchements pleuraux parapneumoniques et des empyèmes. Dtsch Arztebl 2004 ; 101 : A 638-648.
- Bibby AC, Dorn P, Psallidas I, et al. : Déclaration ERS/EACTS sur la prise en charge des effusions pleurales malignes. European Respiratory Journal 2018 ; 52.
- Feller-Kopman DJ, Reddy CB, DeCamp MM, et al. : Prise en charge des effusions pleurales malignes. An Official ATS/STS/STR Clinical Practice Guideline. American journal of respirator y and critical care medicine 2018 ; 198 : 839-849.
- Mathis G : Atlas illustré de l’échographie pulmonaire. 6e édition. Aufl : Springer-Verlag Berlin Heidelberg ; 2016.
InFo PNEUMOLOGIE & ALLERGOLOGIE 2019 ; 1(3) : 18-22